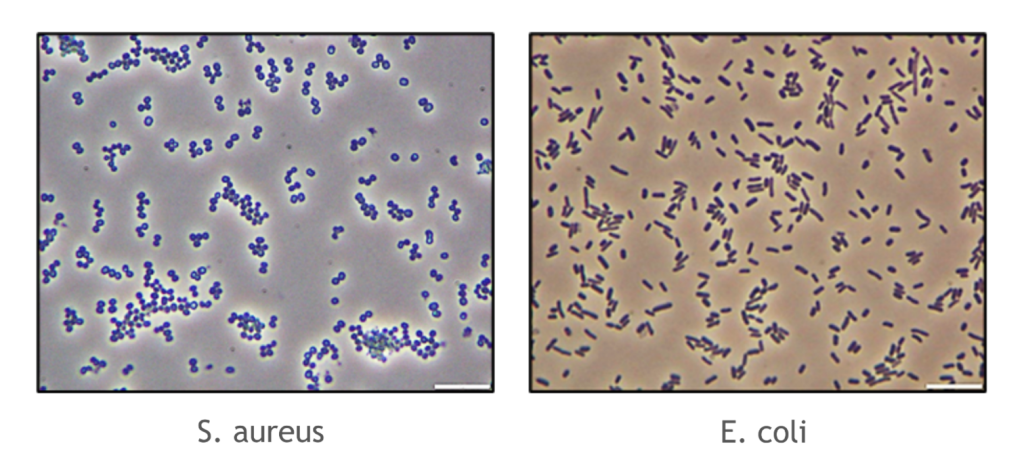

Nous vivons entourés de micro-organismes. Ils sont essentiels à notre santé, mais aussi pour de nombreuses applications, notamment dans l’industrie cosmétique. Nous les utilisons pour garantir que les produits cosmétiques mis sur le marché restent stables face à la contamination microbienne au fil du temps. Quelles sont les applications de la microbiologie en cosmétique ? Qu’est-ce que la conservation des produits cosmétiques ? Commençons par comprendre ce qu’est la microbiologie.
Quel est le rôle de la microbiologie ?
La microbiologie est l’étude des micro-organismes. Elle regroupe tous les organismes microscopiques, classés selon leur espèce. Quels sont les 4 types de micro-organismes en cosmétologie ? Les bactéries, les moisissures, les parasites et les virus.
Les micro-organismes forment un groupe extrêmement diversifié. Ils diffèrent par leur composition, leur forme, leur taille et leur mode de vie. On les trouve partout : dans l’environnement (eau, sol), mais aussi sur notre corps (peau, intestins). Ils peuvent être utilisés également pour la production d’aliments et de boissons fermentés, mais ils sont aussi à l’origine d’inflammations et de maladies.
Comme tout être vivant, ils ont besoin d’une source d’énergie pour croître et se multiplier. En laboratoire, des milieux de culture leur fournissent les nutriments nécessaires à leur développement. Incubés à la bonne température, des colonies apparaissent après quelques jours sur des boîtes de Petri — c’est le cas des bactéries. Pour les moisissures, la croissance se manifeste par un « réseau de filaments » appelé thalle.
L’observation macroscopique de l’apparence des colonies permet de différencier les bactéries contaminantes de celles que l’on cherche à isoler. Il existe une multitude de critères pour identifier un micro-organisme. Pour cela, on utilise des milieux spécifiques appelés « milieux sélectifs » qui limitent la croissance de certaines souches. La différence de composition entre les milieux est la clé pour obtenir une croissance sélective.
Pour compléter l’identification, l’utilisation du microscope permet d’observer différentes formes de bactéries : les coques (cocci) ou les bâtonnets (bacilles), ainsi que différentes couleurs (rose ou violet) obtenues après une coloration de Gram. Par exemple, nous avons ci-dessous un cocci Gram + (S. aureus) et un bacille Gram – (E. coli).
Pourquoi la microbiologie est-elle importante en cosmétique ?
La microbiologie est un paramètre clé dans le développement et la sécurité des cosmétiques. Il est essentiel que le produit que vous utilisez dans votre salle de bain puisse se défendre contre les contaminations extérieures (humidité, prélèvements répétés). Pour éviter la contamination microbienne des cosmétiques, chaque formulation doit être évaluée : Quelle peut être une source de nutriments pour les micro-organismes ? Comment protéger le produit pour le consommateur ?
Pour répondre à ces questions, plusieurs paramètres doivent être vérifiés notamment : la teneur en eau et en alcool de la formule, ainsi que sa stabilité selon les ingrédients ajoutés. Ces vérifications sont nécessaires pour éviter la prolifération microbienne dans les produits cosmétiques.
Si la formulation n’est pas stable, cela peut avoir un impact sur la santé du consommateur. C’est pourquoi la protection du produit est essentielle.
De plus en plus de conservateurs sont retirés des formules en raison des réglementations et des opinions des consommateurs. La tendance des ingrédients naturels représente un vrai défi pour la conservation microbiologique. Conservateurs alternatifs, extraits naturels, emballages biodégradables ou encore forte teneur en ingrédients naturels, représentent autant de nouveaux défis pour garantir la protection du produit final. Des tests obligatoires doivent être réalisés pour assurer la sécurité cosmétique.
Quelles sont les méthodes de test microbiologique en cosmétique ?
La microbiologie en cosmétique repose sur plusieurs tests, tels que : les limites microbiennes acceptables (qualitatives ou quantitatives), l’évaluation du risque microbiologique, le test d’efficacité des conservateurs. Qu’est-ce que la conservation des produits cosmétiques ? C’est un équilibre à trouver entre la protection du produit et la sécurité du consommateur.
Le test d’efficacité des conservateurs, selon la norme ISO 11930, vise à garantir que le produit cosmétique est bien protégé contre les contaminations microbiennes. Pour vérifier que la formule peut se défendre dans le temps et lors de l’utilisation par le consommateur, cinq micro-organismes sont ajoutés à la formulation pour simuler la vie réelle.
Chacun est choisi pour une raison précise : contrôle de l’eau, contrôle de l’air, deux pour la contamination humaine, et un pour le niveau d’hygiène. Après 33 jours d’expérimentation, les résultats obtenus permettent de déterminer la résistance de la formule à la contamination microbienne.

Le test d’efficacité des conservateurs (PET) permet d’évaluer in-vitro le niveau de protection microbienne nécessaire pour la formulation, ainsi que l’efficacité des conservateurs et des ingrédients multifonctionnels (en combinaison). Depuis plus de 30 ans, Symrise développe des solutions d’aide à la conservation efficaces avec pour devise “Faire plus avec moins pour les cosmétiques”.
Comment repenser la conservation des cosmétiques avec de nouvelles solutions de protection ?
Le portefeuille de produits de micro-protection développé par Symrise est composé d’ingrédients multifonctionnels ayant un réel impact sur la stabilité microbiologique du produit fini. Quelle est l’importance principale de la microbiologie en cosmétique ? Trouver la combinaison optimale de protection pour éviter la contamination microbienne.
Parmi une large gamme d’ingrédients multifonctionnels adaptés à la protection moderne des produits, Symrise propose :
- La famille des diols, composée de la gamme Hydrolite®, d’origine synthétique ou naturelle
- Et plus récemment, les nouveautés : Savelite® HB et la gamme Mindera®
Pour garantir la sécurité cosmétique, Symrise compile dans une base de données tous les résultats des tests d’efficacité des conservateurs réalisés sur des cosmétiques. Cette plateforme en ligne innovante s’appelle HOGO. Symrise y a intégré son expertise en tant que fournisseur leader d’ingrédients cosmétiques. Les utilisateurs peuvent facilement rechercher des ingrédients, des données d’efficacité, des combinaisons possibles et des dosages recommandés via HOGO by Symrise. Un système de filtres permet à l’utilisateur de trouver des solutions conformes aux réglementations mondiales. Cet outil en ligne aide les formulateurs à développer le meilleur système de protection, adapté au cahier des charges de leurs projets de formulation. Une efficacité élevée peut par exemple être obtenue en combinant la gamme Hydrolite® range avec SymSave® H, pour garantir une performance à large spectre. Symrise partage également des formules inspirantes via le site internet SymSelect pour guider les clients dans le développement de nouvelles formulations.
La combinaison d’ingrédients multifonctionnels avec d’autres ingrédients et conditions peut offrir une protection plus puissante. La technologie SymShield® développée par Symrise explore les facteurs physicochimiques qui peuvent renforcer la performance des ingrédients multifonctionnels. Elle permet aux formulateurs de maximiser leur efficacité et de les utiliser à des concentrations plus faibles dans les produits finis.
Symrise Cosmetic Ingredients a également lancé une série de formations en ligne intitulée "The Secret Heroes of Personal Care". Disponible sur YouTube, des experts y partagent des connaissances approfondies sur la microprotection des produits de beauté. Grâce à des animations et des histoires captivantes, ces master class informent ceux qui souhaitent en savoir plus sur la science qui se cache derrière leurs produits cosmétiques préférés.
Article écrit par Marine LOUAIZIL , Microbiology Laboratory Manager, Symrise




